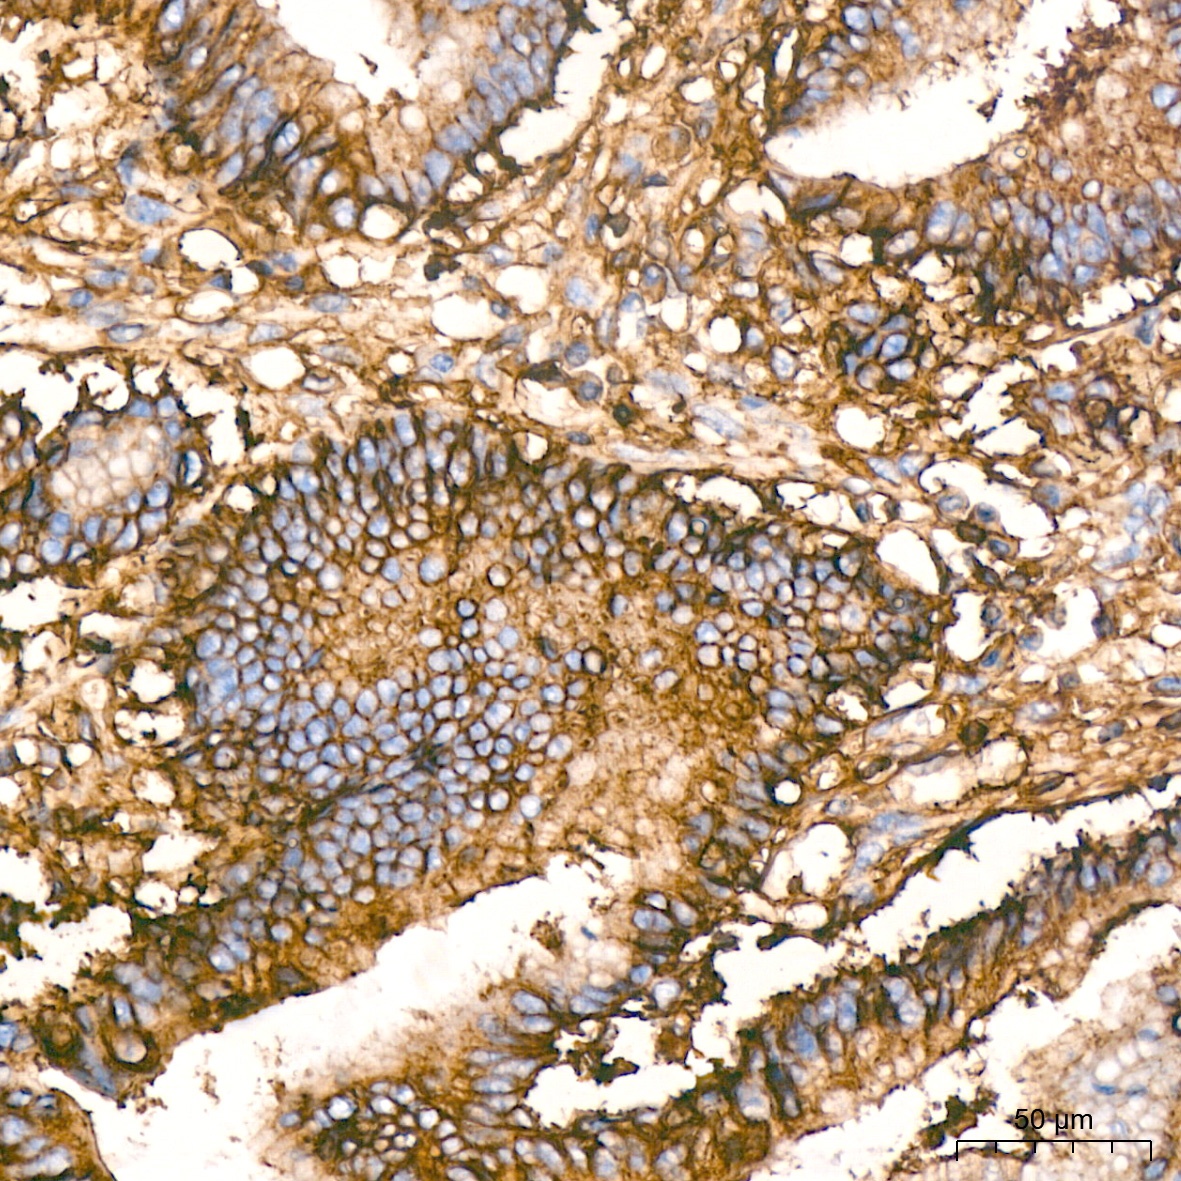
Product Image
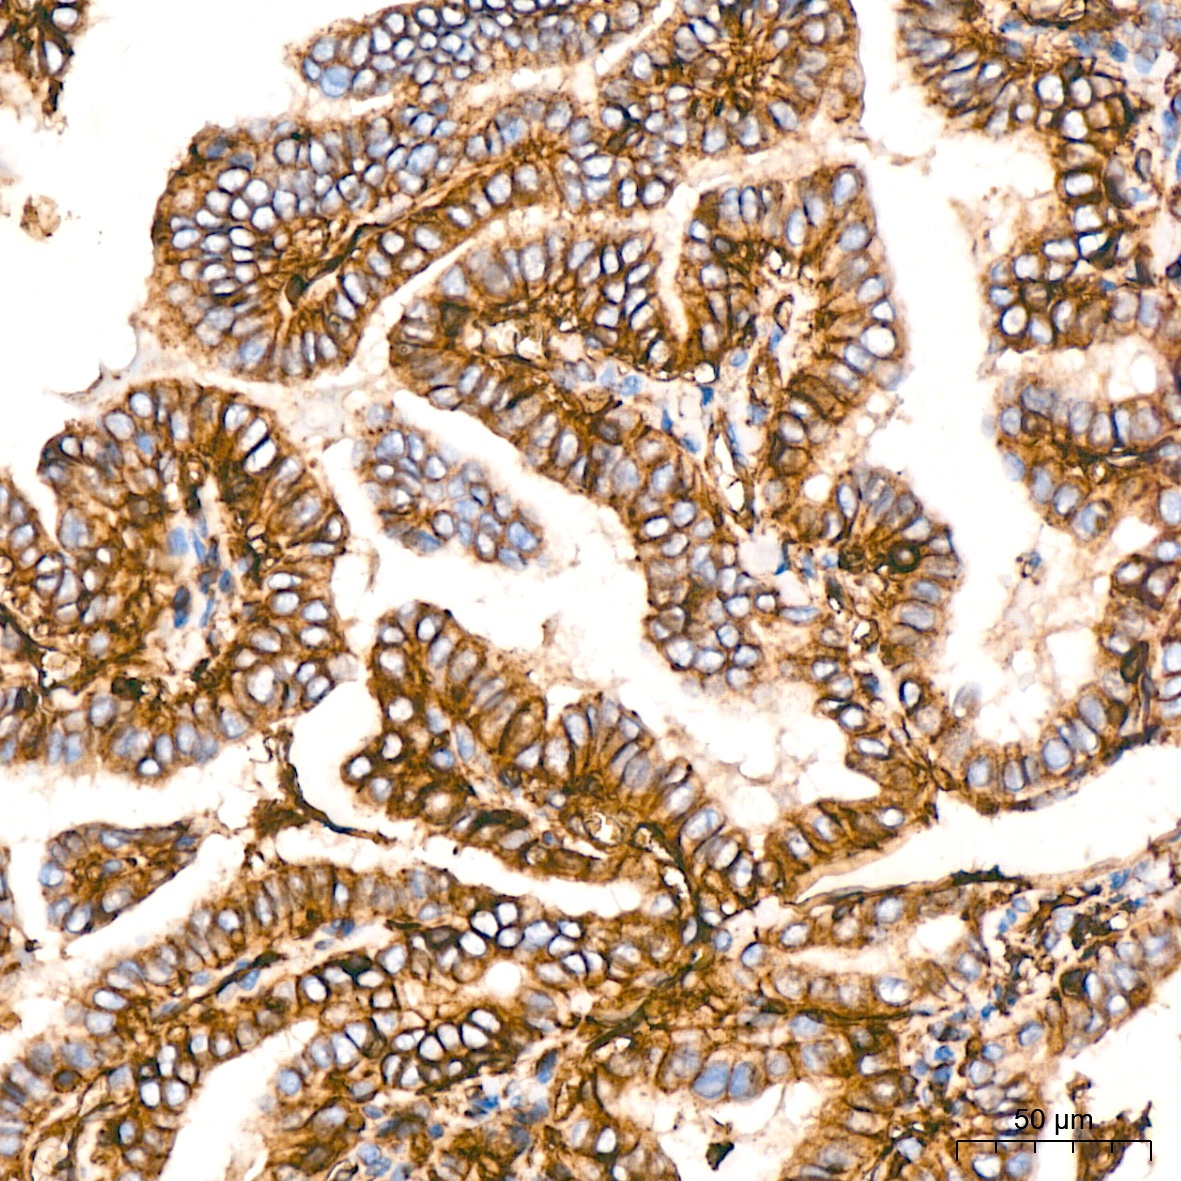
Product Image

HLA-A belongs to the HLA class I heavy chain paralogues. This class I molecule is a heterodimer consisting of a heavy chain and a light chain (beta-2 microglobulin). The heavy chain is anchored in the membrane. Class I molecules play a central role in the immune system by presenting peptides derived from the endoplasmic reticulum lumen so that they can be recognized by cytotoxic T cells. They are expressed in nearly all cells. The heavy chain is approximately 45 kDa and its gene contains 8 exons. Exon 1 encodes the leader peptide, exons 2 and 3 encode the alpha1 and alpha2 domains, which both bind the peptide, exon 4 encodes the alpha3 domain, exon 5 encodes the transmembrane region, and exons 6 and 7 encode the cytoplasmic tail. Polymorphisms within exon 2 and exon 3 are responsible for the peptide binding specificity of each class one molecule. Typing for these polymorphisms is routinely done for bone marrow and kidney transplantation. More than 6000 HLA-A alleles have been described. The HLA system plays an important role in the occurrence and outcome of infectious diseases, including those caused by the malaria parasite, the human immunodeficiency virus (HIV), and the severe acute respiratory syndrome coronavirus (SARS-CoV). The structural spike and the nucleocapsid proteins of the novel coronavirus SARS-CoV-2, which causes coronavirus disease 2019 (COVID-19), are reported to contain multiple Class I epitopes with predicted HLA restrictions. Individual HLA genetic variation may help explain different immune responses to a virus across a population.